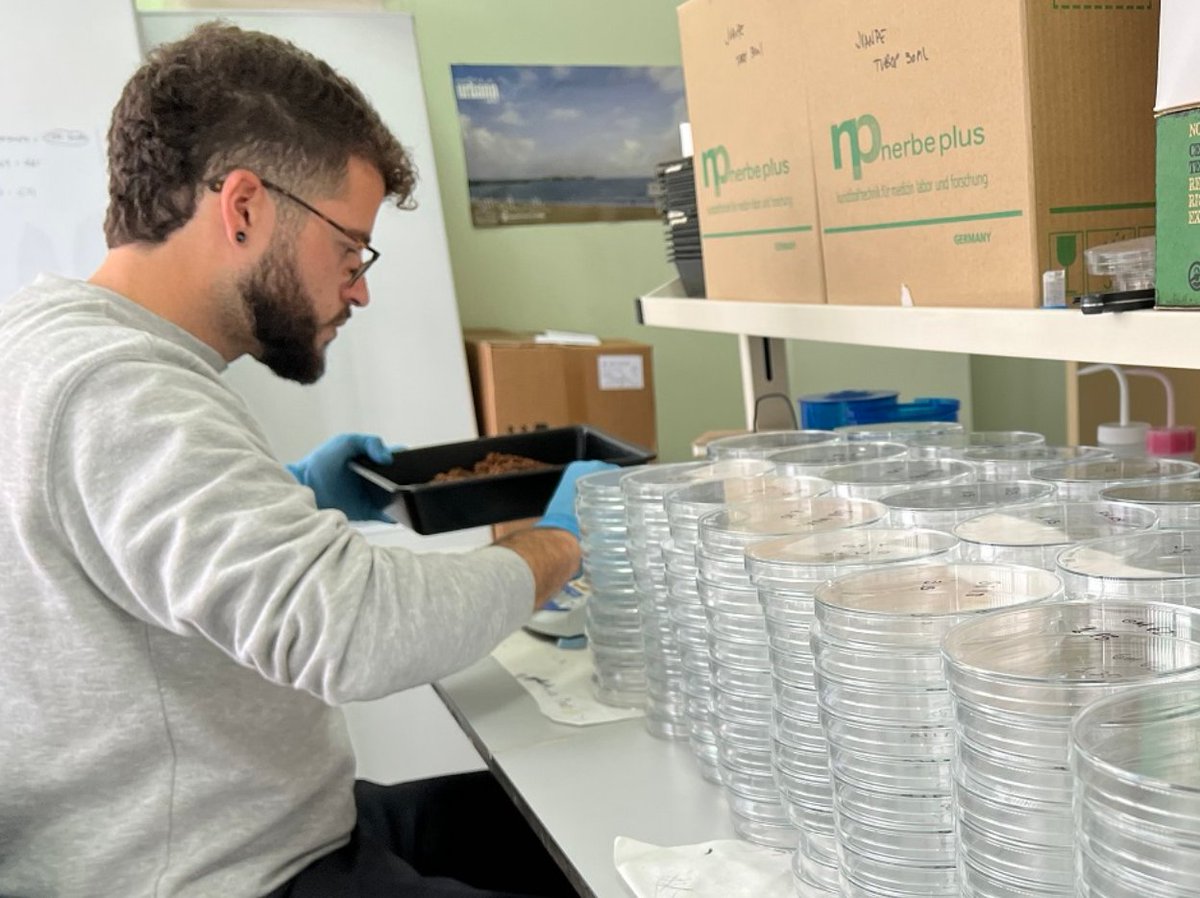
Aplican inoculantes #microbianos para acelerar la transición #ecológica de los #viñedos por <a href="/cei_A3/">ceiA3</a> bit.ly/3WF3BE8

Jose L Blanco Pastor
@jlblancopastor
#botany, #genetics, #biodiversity, #climatechange, #grasslands, #grapevines
ID: 510010507
http://jlblancopastor.com 01-03-2012 10:05:44
675 Tweet
276 Followers
448 Following





¿que hacemos con estas malas hierbas LIFE Olivares Vivos+ ?





#Sevilla también rinde homenaje a sus investigadores jóvenes con la exposición #Sevillatambienescienciajoven! El #CABD como centro mixto tiene el honor de tener en destaque: cvicgar del #CSIC y Suleva Povea de la Pablo de Olavide! 👩🏻🔬👩🏽🔬





Herbaria are invaluable repositories of biodiversity that serve as crucial resources for scientific research, conservation efforts, and education. Show your support to save the Duke University Herbarium: bit.ly/4bRkrbI


#papercake: A nice way to celebrate our Nature Communications paper about heterostyly macroevolution 👉 nature.com/articles/s4146… 🦋🪻 FLAXMaTE Universidad de Sevilla Biología US 👉👉André Marques 👐👐👐


Finishing my talk at #ibc2024. See you Thursday at symposium 9 on genomics and local adaptation organised by Jose L Blanco Pastor